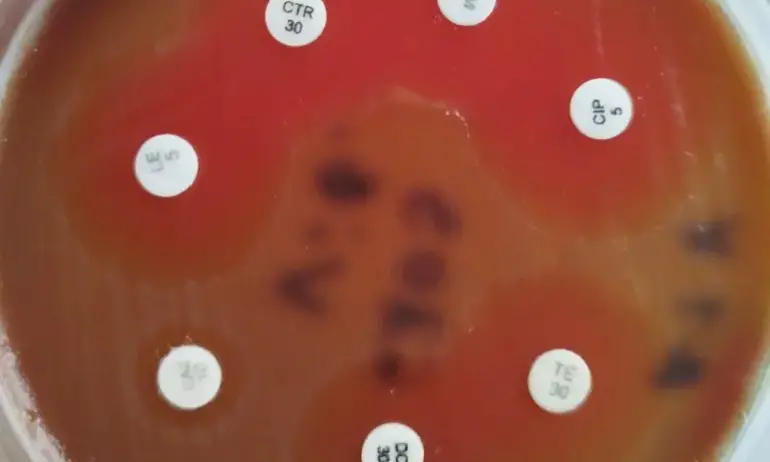
Спасиха жена от бактерия човекоядец в Бургас - Tribune.bg

Спасиха жена от „бактерия човекоядец“ в Бургас
Спасиха жена с рядка, но изключително опасна бактерия - Вибрио вулнификус. При заразяване за часове може да се развие сепсис и да настъпи смърт, затова са наричани "бактерии човекоядци". Жената е спасена в УМБАЛ Бургас, съобщава БНТ.
61-годишната жена е била на почивка на къмпинг Силистар. Наранява крака си на шезлонга, но въпреки откритата рана влиза в морето. Още същият ден кракът се подува, появяват се големи мехури, вдига температура. Пристига в болницата в дежурството на хирурга д-р Тодор Шуплев.
"В България няма данни за човек, оцелял след заразяване по кръвен път. Единственият описан в литературата случай е на белгийски турист, отказал хоспитализация и загинал за часове", посочи д-р Калина Цанкова, началник на Микробиологичната лаборатория в УМБАЛ Бургас.
След като жената е пристигнала в болницата, е установена инфекция и е последвала хирургична обработка на крака, за да не се разпространи бактерията. Взета е и микробиологична проба.
Д-р Калина Цанкова разпознава причинителя веднага, макар че го е виждала само три пъти в своята практика.
"Невъзможно е да объркаш. Тази бактерия е подвижна, характерно е, че не расте в среда, в която растат подобните на нея", обяснява тя.
Незабавно е направена антибиограма, започнато е антибиотично лечение, което паралелно с хирургичното дава резултат, но не веднага. "Имаше момент, в който се появиха симптоми на полиорганна недостатъчност, на сепсис. Жената беше замаяна, не познаваше близките си", разказват лекуващите я лекари.
"Консултираха ни колегите от реанимацията, ползвахме методична помощ и на Клиниката по гнойно септична хирургия в "Пирогов", разказа д-р Тодор Шуплев.
След близо месец борба за живота и десет операции, в които участва целият състав на Втора хирургия, жената е изписана в добро състояние и с два крака – обичайно в подобни случаи се налага ампутация, за да не се разпространи инфекцията.
FaceBook Twitter Pinterest https://tribune.bg/bg/obshtestvo/spasiha-zhena-ot-bakteriya-cho/


